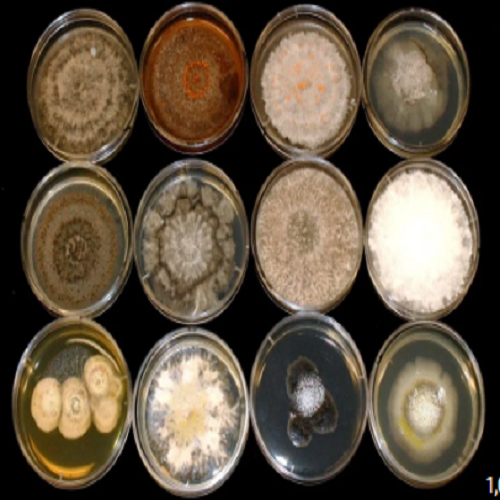

16857 | Prof. Mrityunjaya Agadi |  |
| THE TWO BRANCHES OF INDIAN MUSIC ARE "HINDUSTANI" AND "RNATAK" STYLES |
| |
|
16813 | Dr. Abhishekh Srivastava |  |
| “BAMBOO-BASED ECO-FRIENDLY PRODUCTS AND THEIR MARKET POTENTIAL IN REWA DISTRICT, MADHYA PRADESH” |
| |
|
16780 | Pushkar Rastogi and Dr. Amarjeet Kaur |  |
| ROLE OF TRAINING DATA DIVERSITY IN SHAPING LANGUAGE MODEL PERFORMANCE |
| |
|
16779 | Kshitiz Baveja and Dr. Amarjeet Kaur |  |
| BANK PERFORMANCE AND THE ROLE OF EXTERNAL ECONOMIC CONDITIONS |
| |
|
16766 | Kshitiz Baveja and Dr. Amarjeet Kaur |  |
| HOW BANKS AND OTHER FACTORS INFLUENCE NIM (NET INTEREST MARGIN)?: A SYSTEMATIC REVIEW OF GLOBAL EVIDENCE (1985–2025) |
| |
|
16754 | Manish Pratap Singh |  |
| NANOSTRUCTURED ZINC AND COPPER COMPLEXES FOR ENVIRONMENTAL APPLICATIONS |
| |
|
16753 | Dr. Pushpa Singh |  |
| CLIMATE CHANGE AND GROUNDWATER DEPLETION IN INDIA: TRENDS, CAUSES, AND POLICY RESPONSES |
| |
|
16752 | Deeksha Singh and Dr. Santosh Kumar Agnihotri | |
| ANTIBACTERIAL ACTIVITY OF ENDOPHYTIC FUNGI ASSOCIATED WITH AQUATIC PLANTS |
| |
|
16737 | Dr. Ashwini K. N. |  |
| EFFECT OF EIGHT WEEKS FITNESS TRAINING ON SELECTED PHYSICAL FITNESS COMPONENTS ON HOCKEY MALE PLAYERS |
| |
|
16711 | डॉ. राजेश सिंह कुशवाहा |  |
| समकालीन हिन्दी टी.वी. समाचार चैनलों की भाषिक प्रवृत्ति |
| |
|
16708 | Dr. Meharunnisa H. Hullur |  |
| “WOMEN AND GENDER BUDGETING IN INDIA: A SOCIOLOGICAL ANALYSIS” |
| |
|
16707 | सीतू पटेल, डाॅ. आशुतोष कुमार द्विवेदी |  |
| मन्नू भण्डारी के कथा साहित्य में स्वतंत्रता के पूर्व महिला साहित्यकारों के समाज का अध्ययन |
| |
|
16705 | Sanjay Govekar, Dr. Jojen Mathew and Dr. Vinayak Sopan More |  |
| EFFECTIVENESS OF A LIFE SKILL ENHANCEMENT PACKAGE IN IMPROVING SELF-ESTEEM AMONG B.ED. STUDENTS |
| |
|
16704 | शिमला रानी; डाॅ.जसबीर सिंह |  |
| हिन्दी उपन्यासों में पर्यावरणीय चेतना |
| |
|
16703 | प्रा.डॉ.राखी चंदन मोटघरे (तुरस्कर) |  |
| भंडारा जिल्ह्यातील विकास कार्यक्रमांमध्ये स्थानिक समुदायांचा सहभाग |
| |
|
16702 | प्रा. डॉ. बंडू उत्तमराव जामनिक, डॉ. देवेंद्र पी. सोनटक्के |  |
| भंडारा जिल्ह्यातील ग्रामीण महिलांवर घरगुती हिंसा आणि त्याचा सामाजिक परिणाम |
| |
|
16693 | Laxmi Kanta Ghosh |  |
| ARISTOTLE’S CONCEPT OF CITIZENSHIP |
| |
|
16691 | विजय बहादुर साकेत and डाॅ. गायत्री मिश्रा |  |
| “सीमापार आतंकवाद, राष्ट्रीय सुरक्षा और कश्मीर की आंतरिक स्थिरता: एक नीतिगत अध्ययन |
| |
|
16690 | शिवेन्द्र कुमार पाण्डेय and डाॅ. गायत्री मिश्रा |  |
| “असंगठित श्रमिकों की सामाजिक-आर्थिक दशा एवं विधिक जागरूकता का अध्ययन” (रीवा जिले के संदर्भ में) |
| |
|
16687 | Asst. Prof. Sujata Dasture and Dr. Neha Deo and |  |
| COOPERATIVE LEARNING: A BETTER STEP TOWARDS SUCCESSFUL INCLUSION A study of Effectiveness of Cooperative Learning Strategy Program on Academic Achievement and Emotional maturity of diverse need B.Ed. students. |
| |
|
16684 | चन्द्र कान्त शुक्ल |  |
| प्रसाद के नाटकों के स्वरूप का सामाजिक अध्ययन |
| |
|
16683 | Roshan P. Sadnani and Dr. Anand Thadani |  |
| ROLE OF SECURITY IN ONLINE BANKING SERVICES AND ITS INFLUENCE ON CUSTOMER SATISFACTION |
| |
|
16681 | डॉ. कस्तूरी चक्रवर्ती |  |
| ‘कफन’ : सामाजिक चेतना और यथार्थवाद |
| |
|
16680 | Shivani Soni and Dr. Vijay Francis Peter |  |
| ROLE OF FAMILY AND COACHES IN GROOMING A LEGENDARY HOCKEY PLAYER: A CASE STUDY ON ARJUN AWARDEE SYED JALALUDDIN RIZVI |
| |
|
16664 | Dr. Amritpal Kaur |  |
| INCLUSION AND EQUITY IN EDUCATION: UNDERSTANDING NEP-2020’S EMPHASIS ON INCLUSIVE EDUCATIONAL TRANSFORMATION |
| |
|
16663 | Dr. Deepika Swarnkar |  |
| AN INSIGHT ON AN EPIC OF INDIAN VALUES AND DHARMA: “THE RAMAYANA” |
| |
|
16660 | डाॅ. संजीव कुमार, प्रोफेसर (डाॅ.) ओम दत्त |  |
| सूचना का अधिकार अधिनियम- 2005 की धारा 18 एवं धारा 19ः- एक तुलनात्मक अध्ययन |
| |
|
16659 | रेखा सोनी, डाॅ. आर.के. सोनी |  |
| रीवा जिले की ग्रामीण महिलाओं में शिक्षा के प्रसार और सामाजिक परिवर्तन का अध्ययन |
| |
|
16658 | डाॅ. रमाकांत शर्मा |  |
| भगवान राम के वनगमन पथ मार्ग का पर्यटन विकास एवं राष्ट्रीय एकीकरण पर प्रभाव का अध्ययन |
| |
|
16657 | Dr. Umesh Singh Kushwah |  |
| MARKETING OF LIBRARY AND INFORMATION PRODUCTS AND SERVICES- A DIGITAL MARKETING APPROACH |
| |
|
16655 | Dr. Debasish Bhattacharjee |  |
| UNIVERSAL APPROACH OF VEDIC CULTURE AND TRADITION |
| |
|
16637 | पायल चुघ |  |
| मध्यवर्गीय परिवारों में महिलाओं के मानसिक स्वास्थ्य पर योग और ध्यान का प्रभाव: एक समग्र विश्लेषण |
| |
|
16636 | Dr. H. M. Natikar |  |
| LACK OF WOMEN'S REPRESENTATION AND FEMALE CANDIDACY IN POLITICS - CAUSES AND SOLUTIONS |
| |
|
16635 | Dr. Shivaji Ramachandra Katti |  |
| HUMAN RIGHTS AWARENESS AND SENSITIZATION - UNDERSTANDING THE ROLE OF EDUCATIONAL INSTITUTIONS |
| |
|
16632 | Dr. P.Pazhaniraja and R. Akshaya |  |
| ANTIBACTERIAL ACTIVITY OF ETHANOL EXTRACT OF Aegle Marmelos(LEAVES) AGAINST HUMAN PATHOGENS |
| |
|
16617 | Nisha Mohankar and Prof. Dr. Rajvilas R. Karmore |  |
| ROLE OF COST ACCOUNTING AND COST CONTROL TECHNIQUES IN PROFITABILITY MANAGEMENT OF DAIRY INDUSTRIES OF MAHARASHTRA |
| |
|
16616 | Abhijit Das and Dr. Salam Anand Singh |  |
| REGENCY, ACCESSION, AND THE CHALLENGES OF PERIPHERAL STATE FORMATION: TRIPURA’S INTEGRATION INTO THE INDIAN UNION, 1947–1949 |
| |
|